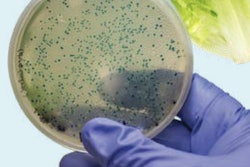
Contamination testing and adherence to third-party standards play a significant role in sanitation compliance.

End users of food and beverage equipment say they face several challenges when it comes to sanitizing machinery, which revolve around the size of parts that need cleaning, measuring sanitation, and moisture conditions.
That’s according to PMMI Business Intelligence’s “Food Safety and Sanitation Trends: End User, OEM, and Supplier Perspectives,” a report that explores the essentialism of adhering to food safety regulations and effectively executing sanitation strategies through information on regulations, strategies, and exclusive insight. The report’s findings are based on 130 surveys/interviews with industry professionals, 77% of whom are CPGs or contract packagers, and 23% who are OEMs and suppliers.
Of the surveyed industry professionals, 33% indicated sanitizing small parts and components as a top challenge, while 28% noted validating and measuring sanitation effectiveness as the next biggest obstacle. Finally, 23% voted condensation, pooling, and employee trapped moisture as the third largest challenge.